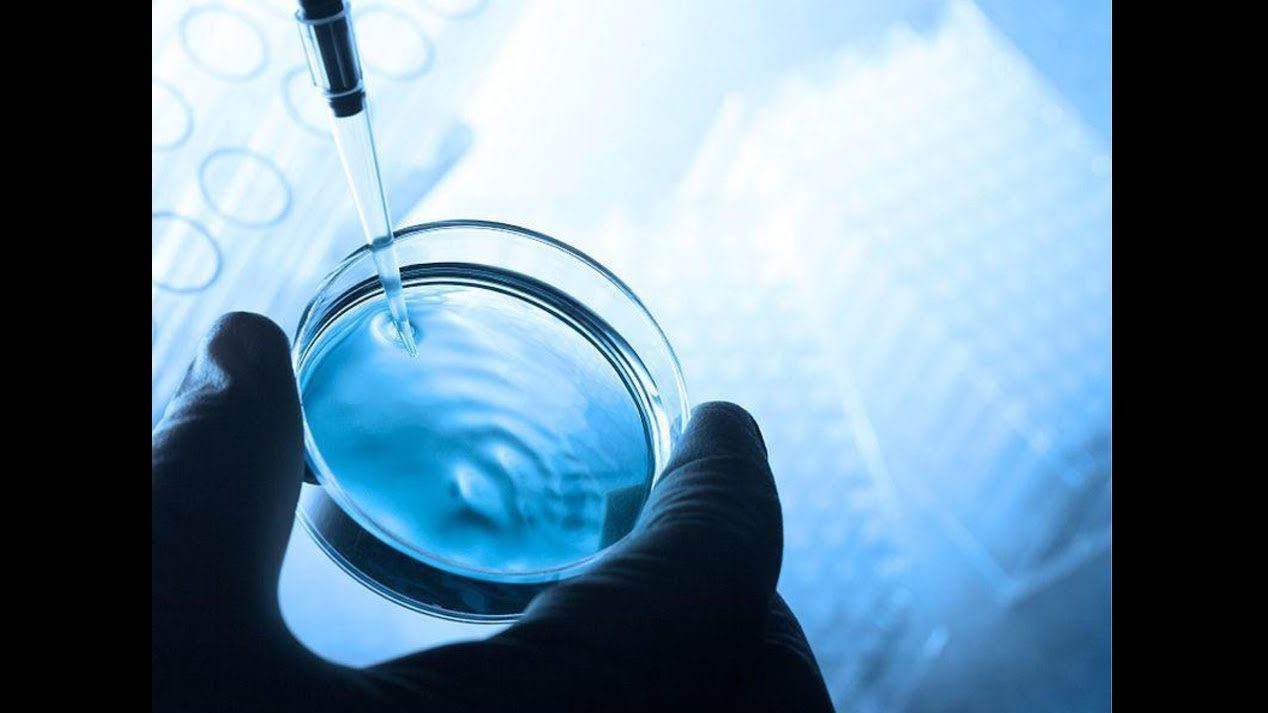

Río en Indonesia
© Curt Carnemark / World BankPhoto
El agua de los ríos y acuíferos de ahora no es la misma que la de hace 10 años, ni aquella de la de hace 20. Tampoco sabemos con exactitud cuál será el estado del agua en el futuro, pues el cambio climático y la contaminación seguirán alterando su ciclo en la Tierra, un planeta que en 2030 estará habitado por cerca de 9.000 millones de personas. Tenemos que eliminar esta incertidumbre para poder alcanzar la gestión eficaz de los recursos hídricos, un factor clave para la consecución de los Objetivos de Desarrollo Sostenible (ODS).
I+D+i, con todas las letras
Los países más avanzados son los que tienen que liderar la estrategia que lleve a la adopción de la economía circular. Es el modelo que va a permitir que los recursos lleguen a todos en un mundo en el que sea digno vivir, a pesar de que, según la opinión de muchos ecólogos, esté ya en fase de “hibridación”, avanzando hacia una clase planetaria completamente nueva.
Los que sostienen esta teoría consideran que las ciencias naturales tienen que reconsiderarse y adaptarse a un objeto científico constantemente alterado por la acción humana. El agua, el elemento quizá más vulnerable por la contaminación y el cambio climático, es un buen ejemplo.
En este vídeo Damià Barceló, director del Institut Català de Recerca del Aigua (ICRA), nos da una idea de la magnitud del problema al explicar el uso de “ríos artificiales” para estudiar los ecosistemas acuáticos:
Conservar el ciclo del agua es un reto insólito en la historia de la humanidad que nos obliga a aplicar el concepto del I+D+i a escala global: Investigar (I) con la ciencia para conocer cuanto más sea posible lo que le ocurre al agua y poder aplicar luego este conocimiento en innovación (i) tecnológica y modelos de gestión eficaces para lograr desarrollo socioeconómico (D).
Es una ecuación simple que sin embargo nos obliga a hacer un esfuerzo en objetividad e inteligibilidad para que el conocimiento sea útil y llegue a ser comprensible para la población, factor decisivo para obtener el beneficio socioeconómico.
Una referencia de los retos que afronta la investigación e innovación con respecto al agua es la creación de la Water JPI, la Iniciativa de Programación Conjunta del Agua, por parte de la Unión Europea con el objetivo de definir “los desafíos del agua para un mundo cambiante y lograr sistemas de gestión del agua sostenibles”.
Europa es un buen banco de pruebas de la imprescindible transversalidad internacional para que los esfuerzos en I+D+i sean eficaces y poder ampliar luego la experiencia a otras zonas del mundo. El 30 % de los europeos sufren estrés hídrico. Esta proporción es más acusada en los países mediterráneos como España, Italia, sur de Francia, Malta y Grecia que además son los más amenazados por los fenómenos extremos como sequías e inundaciones, aunque los países del norte también afrontan un creciente desequilibrio. La Unión Europea prevé que en 2030 la diferencia entre la disponibilidad de agua y la demanda haya aumentado en un 50 % de media en sus estados miembros. Es una situación que permite establecer cierto paralelismo con la de otros países “multiclimáticos” como EEUU, China y buena parte del territorio de India.
La agricultura es clave
En el sur de Europa la agricultura absorbe más del 70% del agua dulce, una proporción similar a la del promedio mundial, que la FAO estima alcanzará casi el 85 % en 2030. Aplicar el I+D+i al uso del agua en la agricultura es prioritario ya que además del enorme volumen absorbido, en casos de crisis hídricas los cultivos precisan agua inmediatamente, mientras otros sectores como la industria y el suministro urbano tienen más margen para racionar el consumo.

©Alberto Gonzalez Rovira
Los retos del I+D+i aplicado a la agricultura pasan por diseñar y aplicar sistemas de regadío eficientes que minimicen las pérdidas pero también la innovación debe aplicarse a los modelos de crecimiento, y aquí el problema es más complejo pues están implicados muchos factores socioeconómicos. En el sur de Europa, por ejemplo, como en muchas otras zonas del mundo semiárido, el sol y el calor han propiciado el desarrollo de cultivos de hortalizas que requieren mucha agua en zonas donde hay poca, y estos cultivos son esenciales para la economía local.
En el debate del pasado Día Mundial del Agua que organizó la Fundación We Are Water con expertos en meteorología y tratamiento del agua, quedó de manifiesto esta contradicción climática. Xavier Torras, director de la Fundación, señaló la importancia de encontrar caminos de innovación que lleven a no encarecer el agua de los cultivos y a evaluar con exactitud la huella hídrica de los productos servidos: “Si llevamos agua cara a la huerta, los productos finalmente no serán competitivos, lo que puede afectar gravemente a la economía de las zonas. Hay que evaluar estos procesos ya que el volumen de agua que se trasvasa en las transacciones comerciales de un sitio a otro incorpora la huella hídrica de los productos. Y es evidente que el consumo agrícola de cercanía causa menos estrés hídrico”.
La agricultura tiene que desarrollar modelos circulares sostenibles y permitir así que los acuíferos sean reservas naturales de agua, no fuentes de primera instancia, actitud que ha llevado a una sobreexplotación alarmante y a un desequilibrio entre cuencas que es un desencadenante de constantes tensiones sociales.
Acabar con la contaminación difusa
Tanto la agricultura como la silvicultura han causado y están causando altos niveles de contaminación difusa del agua, la más difícil de controlar, a causa de los fertilizantes y pesticidas que han inundado las cuencas hidrológicas, los acuíferos y el océano, afectando la calidad del agua de casi todo el mundo, aumentando los costes de potabilización y depuración, y llegando en algunas zonas a colapsar el crecimiento económico.

La obra “Gyre” de Chris Jordan muestra 2.4 millones de piezas de plástico, igual a la cantidad estimada de libras de contaminación plástica que se vierte en los océanos del mundo cada hora. Todo el plástico que compone su imagen fue recolectado del Océano Pacífico.
©Gyre / Chris Jordan
Los hidrólogos y los oceanógrafos están estudiando los desequilibrios creados en los ecosistemas, como la eutrofización de las zonas costeras causada por fertilizantes como los nitratos que constituyen la mayor fuente de contaminación difusa de las aguas de Europa y Norteamérica.
Esta contaminación se produce por un excesivo uso de fertilizantes y por la inadecuada gestión de los residuos de las explotaciones ganaderas. Los proyectos Life Nitratos y Life sigAGROasesor de la Unión Europea son buenos ejemplos de cómo la innovación (i) en la gestión a partir de los datos de las mediciones (I) puede reducir notablemente este tipo de contaminación del agua (D), como ha ocurrido en Navarra con la aplicación del proyecto por parte del INTIA.
La contaminación por microplásticos también puede considerarse como difusa ya que la fuente es múltiple, pues no sólo proviene de determinadas malas prácticas industriales sino de los miles de millones de consumidores que en todo el mundo arrojan al medio natural o a las alcantarillas todo tipo de utensilios domésticos. Según la Fundación Ellen MacArthur, cada año se lanzan al mar 8 millones de toneladas de plásticos que al degradarse se convierten en partículas menores de 5 mm de diámetro debido a la acción del sol, a la oxidación y a la acción física de las olas. De seguir así, algunos oceanógrafos vaticinan que en 2050 habrá un volumen mayor de plástico que de peces en el mar.
Eliminar las micropartículas contaminantes en el agua es imposible a corto plazo, pero sí que podemos frenar drásticamente su incremento adoptando la economía circular, optando por la producción de plásticos biodegradables y por la educación de los usuarios de estos productos, que somos todos, en el reciclaje y el buen uso de las instalaciones de saneamiento.
Contaminantes emergentes
Los usuarios domésticos somos los principales responsables de buena parte la contaminación emergente, que es la que ha sido detectada recientemente y sobre la que las Administraciones aún no han dictaminado medidas restrictivas ya que los científicos aún no han determinado con exactitud su grado de nocividad para el medio ambiente y las personas. Rafael Mantecón, ingeniero químico y coordinador de saneamiento del Área Metropolitana de Barcelona (AMB), resume el reto que la gestión del agua y los contaminantes emergentes plantean al I+D+i:

Como señala Mantecón, una buena parte de la contaminación emergente de origen domestico proviene del uso de fármacos como antiinflamatorios y analgésicos, antidepresivos, anticonceptivos, antibióticos, reguladores del colesterol… que han experimentado un gran consumo las últimas décadas y que excretamos por la orina en aproximadamente un 50 %. Es un tipo de contaminación que va asociada al incremento de la calidad de vida y es por tanto preocupante en el camino hacia la consecución de los ODS. La mayor parte de estos contaminantes no pueden eliminarse en las actuales depuradoras y aquí el I+D+i debe procurar no sólo nuevos sistemas de detección sino posibles tratamientos de eliminación.

©Laura Iniesta
Los contaminantes difusos y los emergentes ponen en evidencia la necesidad de cambios de modelos en política de agua. Esta debe estar integrada en marcos estales y no, como ocurre en muchos países, estar sujeta a vaivenes legislativos gubernamentales para poder desarrollar los adecuados incentivos económicos para el éxito. Estos marcos deben de ser transversales internacionalmente, como señala la ONU en la definición de los ODS, para que la experiencia en la gestión de las comunidades más avanzadas pueda globalizarse en beneficio del equilibrio social y medioambiental del planeta.






